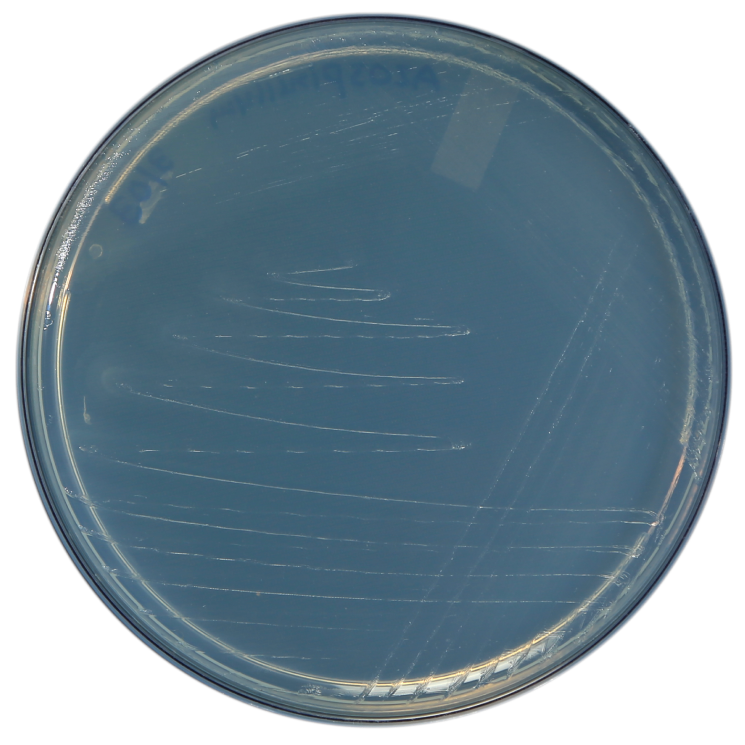
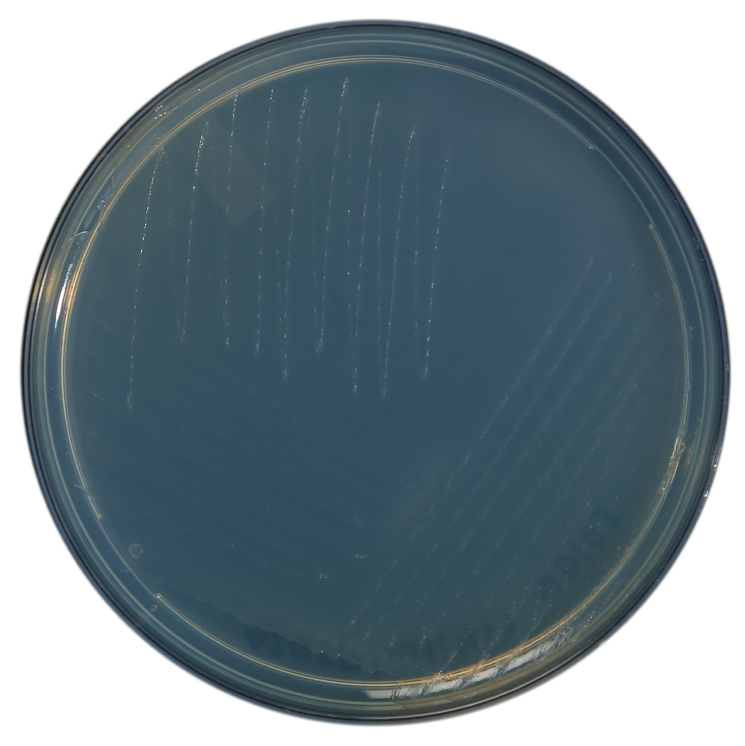
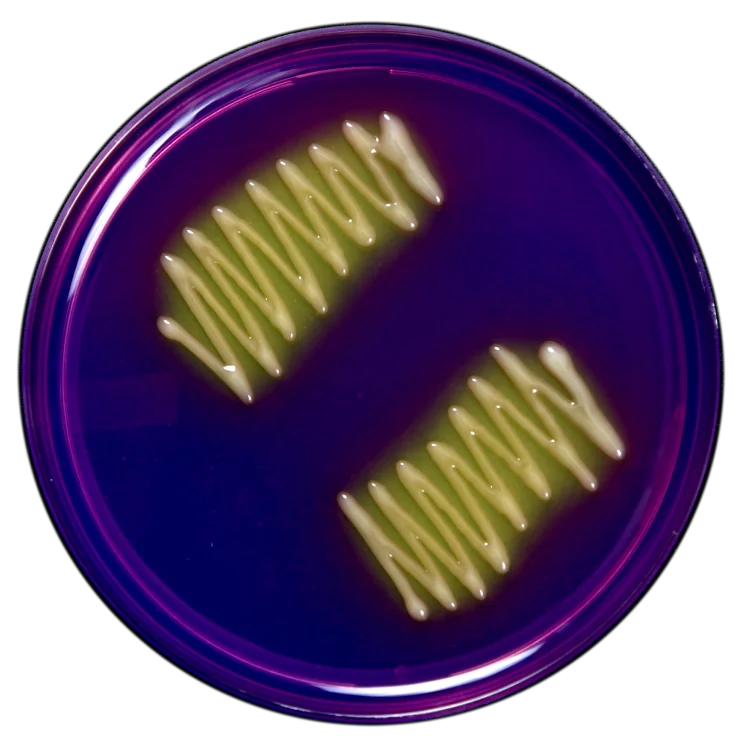
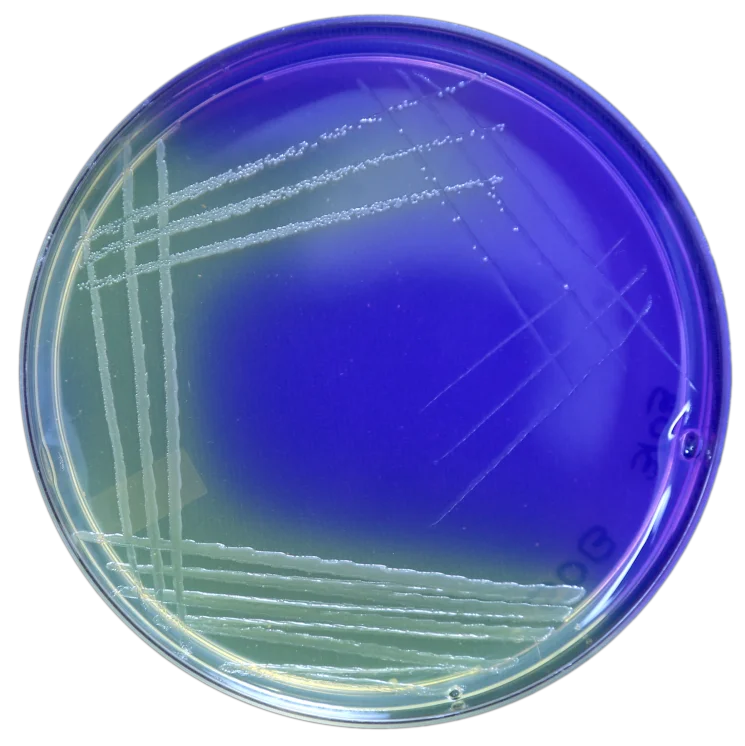
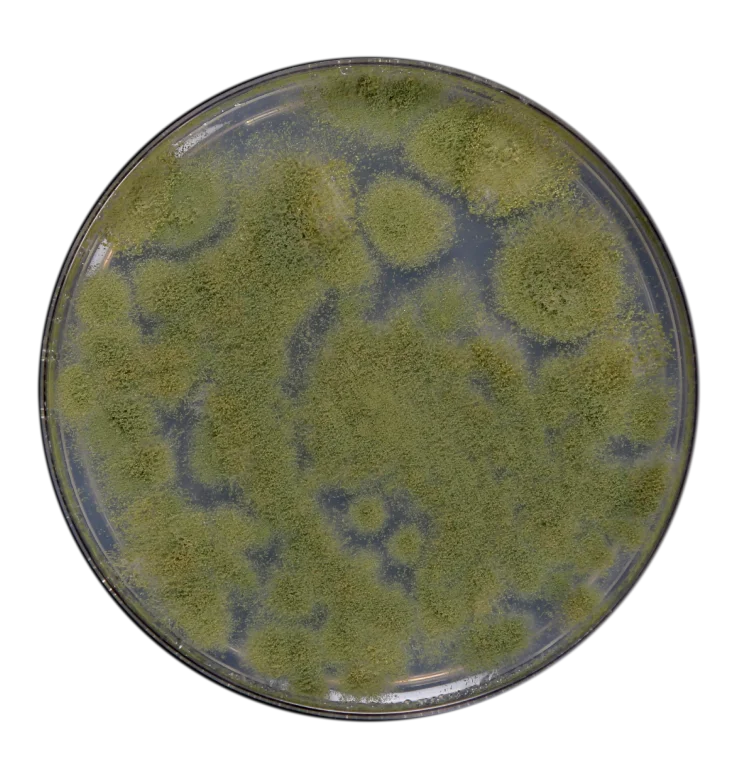
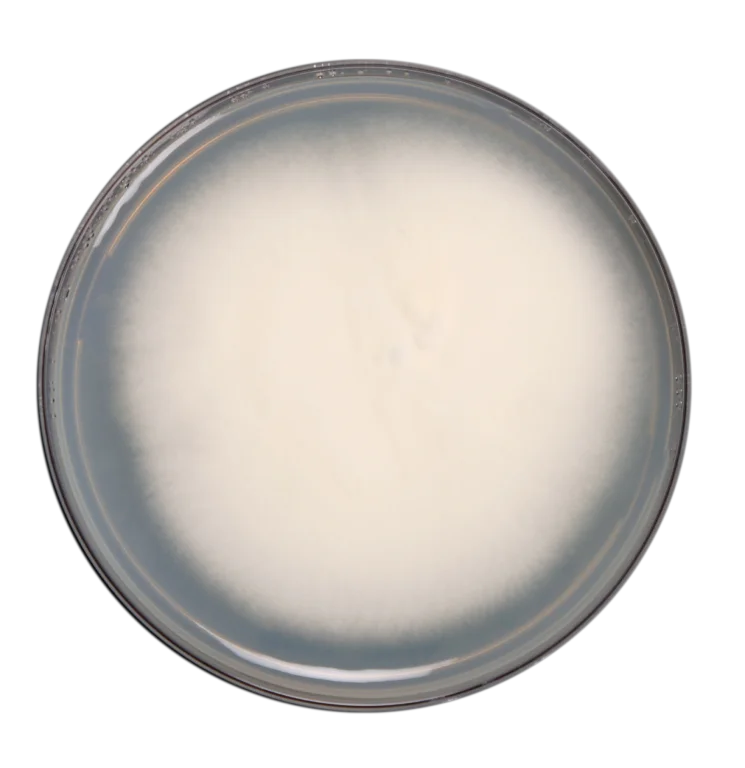
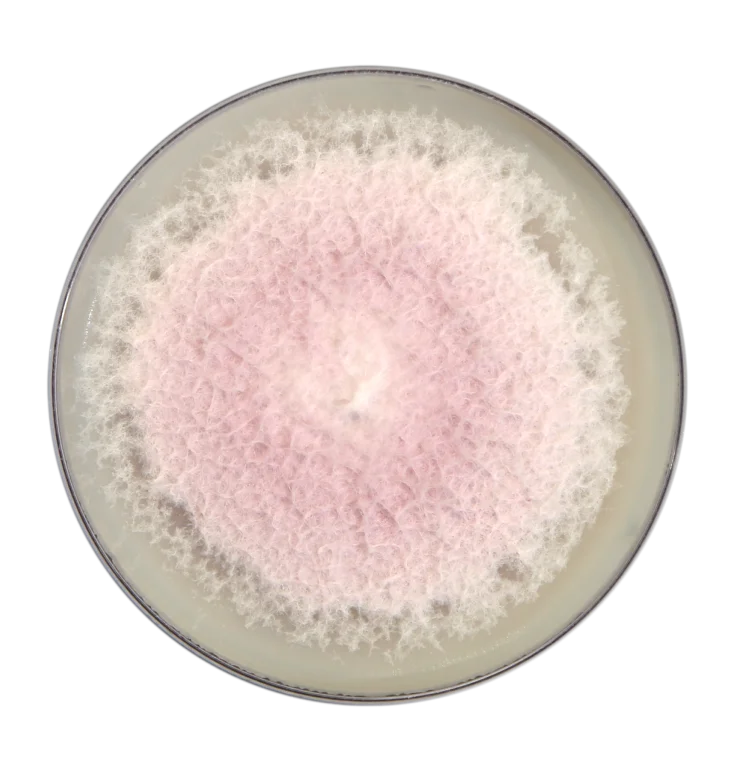
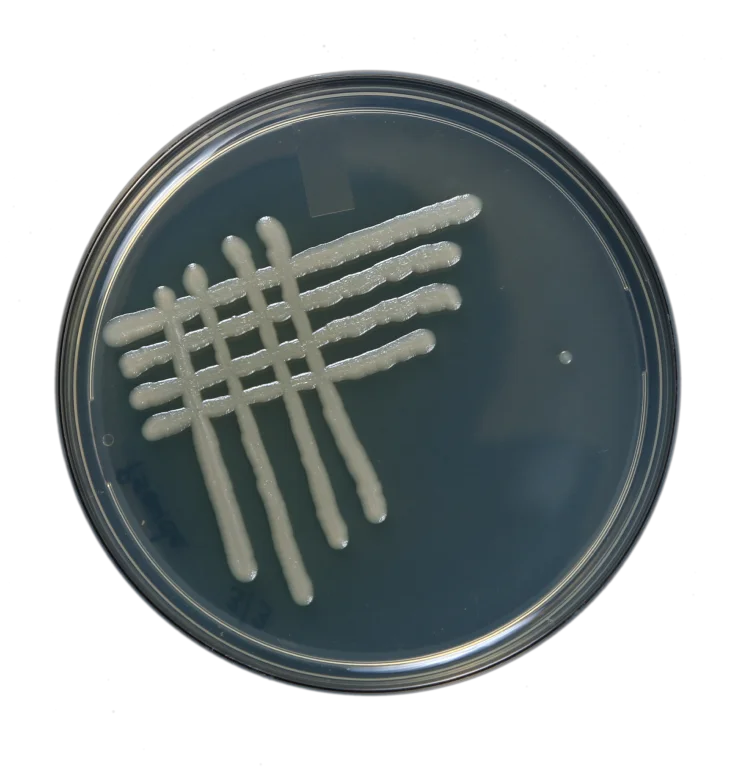
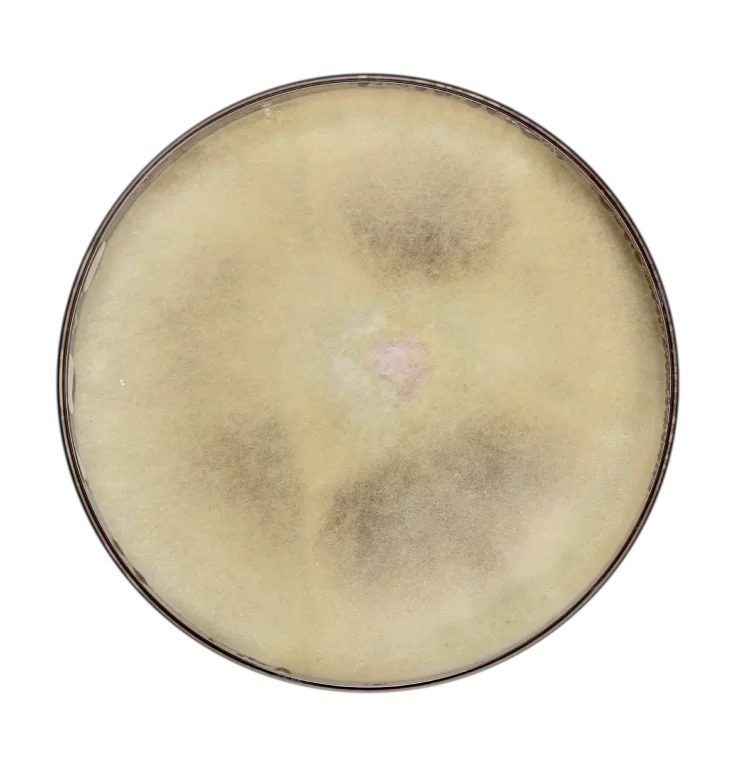
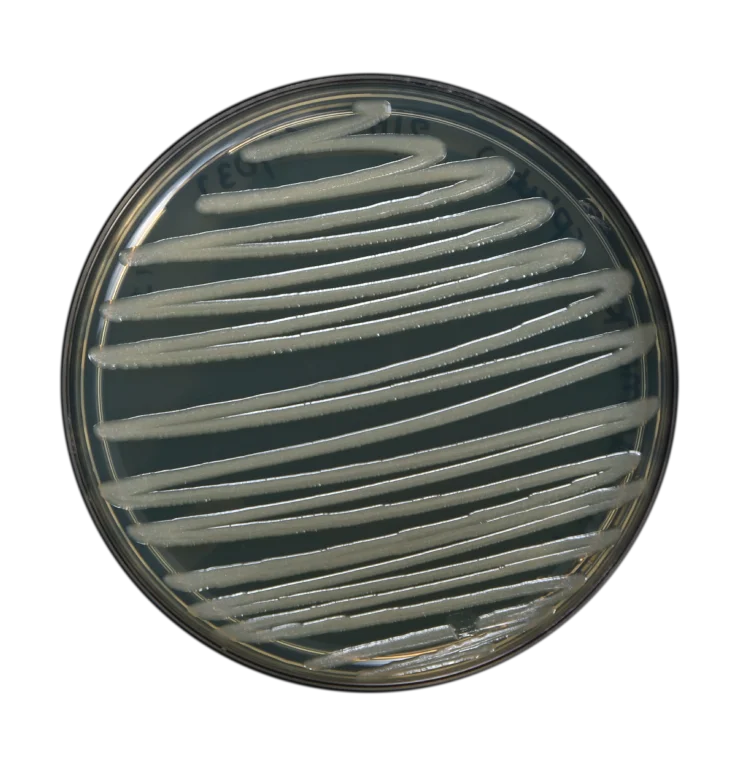

“Providing Quality Fertilizers for Enhanced Crop Yield”
We are dedicated to supplying high-quality fertilizers to support agricultural growth and enhance crop yield. With a focus on innovation, sustainability, and customer satisfaction, we strive to be a trusted partner for farmers and agricultural professionals worldwide.
At Arihant Group of Industries, we produce a wide range of bulk agriculture products tailored to meet the diverse needs of modern farming practices. Our product offerings include:
Utilizing natural ingredients and sustainable practices, our organic fertilizers provide essential nutrients to soil and plants without harmful chemicals or synthetic additives.
Read More..Our NPK blends are carefully formulated to deliver a balanced combination of nitrogen (N), phosphorus (P), and potassium (K), tailored to specific crop requirements for optimal growth and development.
Read More..
We offer a variety of micronutrient supplements to address nutrient deficiencies in soil and promote healthy plant growth, ensuring maximum yield and quality.
Read More..
In addition to our standard product offerings, we also provide custom formulation services, allowing farmers to create personalized fertilizers tailored to their unique soil and crop needs.
Read More..

















NPK Liquid Gel Fertilizer
Urea, for ages, has been considered one of the best sources of Nitrogen for plants. It is very helpful in the growth and development of crops during crucial stages. Nitrogen compounds synthesize amino acids and nucleic acids. Urea, a source of Nitrogen, helps plants improve root development and promote lushness in the leaves.
Learn MoreNPK Liquid Gel Fertilizer
It is the most concentrated phosphate-based fertilizer a farmer can get. A perfect solution for the phosphorus nutrition requirements of plants. Phosphorus is an essential nutrient for plants when it comes to RNA and DNA formation of the plants.Since this Liquid has Phosphorus in principal amounts, it also helps in cell division and facilitates growth during root development stages.
Learn MoreNPK Liquid Gel Fertilizer
Our NPK Liquid 24:24:00 ,an emulsion based slow release fertilizer, is a powerful solution designed to meet the specific nutritional needs of your plants and promote vigorous growth.An equal ratio of nitrogen (N) and phosphorus (P) in a fertilizer plays a vital role in supporting plant growth and development.
Learn MoreNPK Liquid Gel Fertilizer
Arihant’s emulsion-based slow release Liquid NPK 00:00:46.5 focuses on the deficiency or requirement of Potassium in the plants. Potassium (K) essentially plays a significant role in plant physiological processes. Therefore, it is required in large amounts for proper growth and reproduction in plants.
Learn MoreNPK Liquid Gel Fertilizer
Arihant’s Emulsion-based slow release Liquid NPK 00:00:50 contains a high concentration of potassium, a vital macronutrient for plants. Potassium plays a crucial role in various plant functions, including photosynthesis, nutrient absorption, water regulation, and disease resistance.
Learn MoreNPK Liquid Gel Fertilizer
A mixture fertilizer consisting of Nitrogen and Potassium, Arihant’s Emulsion-based slow release liquid NPK 10:00:40 focuses on the deficiency or requirement of Potassium in the plants in addition to a small portion of Nitrogen. Potassium (K) essentially plays a significant role in plant physiological processes.
Learn MoreNPK Liquid Gel Fertilizer
Our Fortified NPK 07:21:00 Liquid Fertilizer, is a powerful solution designed to meet the specific nutritional needs of your plants and promote vigorous growth.Our formula prioritizes nitrogen and phosphorus for unparalleled crop performance.The substantial nitrogen content fuels robust vegetative growth.Phosphorus promotes extensive root development, ensuring strong anchorage and nutrient absorption.
Learn MoreNPK Liquid Gel Fertilizer
PKB 35:30:08, an emulsion-based liquid fertilizer is a high-quality formulation designed to meet the nutritional needs of plants. It contains a precise combination of essential nutrients, including phosphorus (P), potassium (K), and boron (B). This specific ratio of nutrients is carefully formulated to support robust growth, healthy root development, and improved crop yield.
Learn MoreNPK Liquid Gel Fertilizer
An Emulsion-based liquid gel mixture fertilizer made from the combination of the two essential macronutrients Phosphorus and Potassium. A combination that delivers both these nutrients in equal proportion leads to enhanced root development, strong stem and stalk and a robust DNA and RNA as well as getting a wide range of helpful enzymes helping the plant growth. It also plays a role in the stress-fighting strength of the crop with the movement of water within the plant.
Learn MoreNPK Liquid Gel Fertilizer
A product that is one of the most widely used variations of the NPK mixture fertilizers is NPK 19:19:19 which arguably is the most equitable mixture of all the three macronutrients.With Nitrogen, Phosphorus, and Potassium present in an equal ratio of 19:19:19 respectively.
Learn MoreNPK Liquid Gel Fertilizer
Our Emulsion-based NPK Liquid Gel 20:20:20 is a high-quality liquid gel fertilizer designed to provide balanced nutrition to plants. This innovative formula utilizes innovative technology to create a stable and highly efficient emulsion, ensuring maximum nutrient absorption and utilization by plants.
Learn MoreNPK Liquid Gel Fertilizer
NPK Liquid Gel 25:25:25 an emulsion-based liquid fertilizer is a balanced nutrient formulation that provides plants with essential nitrogen (N), phosphorus (P), and potassium (K) in a convenient liquid form. This fertilizer offers farmers a range of benefits, including balanced nutrition for healthy plant growth, ease of application, uniform nutrient distribution, enhanced nutrient uptake, potential controlled-release properties, and versatility across various crops.
Learn MoreNPK Liquid Gel Fertilizer
Arihant's emulsion-based slow -release liquid gel fertilizer, NPK 10:10:50:02, is specifically formulated to address potassium deficiency or requirements in plants. It provides an equal portion of nitrogen and phosphorus, along with the added benefit of the micronutrient boron.
Learn MoreNPK Liquid Gel Fertilizer
An emulsion-based slow release liquid gel Fertilizer NPK 12:32:16 is a complex fertilizer with a high concentration of phosphorus compared to nitrogen and potassium. This balanced nutrient composition can be beneficial for plants, especially during specific growth stages.
Learn MoreNPK Liquid Gel Fertilizer
A complex fertilizer mixture of all three primary macronutrients, NPK Liquid gel 20:10:10 is a comprehensive solution that delivers Nitrogen (N), Phosphorus (P), and Potash/Potassium (K) in a fixed ratio.
Learn MoreNPK Liquid Gel Fertilizer
Unlock the potential of your crops with our advanced NPK Liquid Gel 11:11:08, a power-packed solution meticulously crafted to cater to the nutritional needs of plants during critical growth stages. This suspension formula, enriched with essential micronutrients like Zinc as ZnEDTA and Boron as B , ensures a robust and comprehensive approach to plant nutrition.
Learn MoreNPK Liquid Gel Fertilizer
NPK Liquid Gel 08:08:08 is Fully water soluble balanced fertilizer enriched with micronutrients. It provides all the nutrients for healthy and balanced growth of all plants.
Learn MoreNPK Liquid Gel Fertilizer
Liquid Nitrogen N 46 is a high-efficiency nitrogen fertilizer designed to provide sustained and controlled nitrogen release for optimal crop growth. Formulated with 35% Nitrogen (Wt/Wt) and 46% Nitrogen (Wt/Vol), this innovative liquid fertilizer ensures an extended nutrient availability period, reducing nitrogen losses and maximizing plant uptake efficiency. With its advanced slow-release mechanism and patented technology, Liquid Nitrogen N 46 provides a game-changing solution for farmers seeking sustainable and highly efficient nitrogen management. This innovative liquid fertilizer ensures long-lasting nitrogen availability, reduces input costs, and supports healthy, high-yielding crops with minimal environmental footprint.
Learn More















Organic + NPK Liquid Gel Fertilizer
Arihant’s Organic + Zincated N-46 is an emulsion-based slow release liquid fertilizer with added benefits of Zinc.
Learn MoreOrganic + NPK Liquid Gel Fertilizer
Arihant’s Organic + Liquid Urea with Organic component - 4% and N-44% is an emulsion-based slow release liquid fertilizer.
Learn MoreOrganic + NPK Liquid Gel Fertilizer
Arihant’s Organic + Liquid Urea with Organic component - 20% and N-44% is an emulsion-based slow release liquid fertilizer .
Learn MoreOrganic + NPK Liquid Gel Fertilizer
Arihant’s Organic +Dap Liquid 18:46:00 is the most concentrated phosphate-based fertilizer a farmer can get. A perfect emulsion-based slow- release liquid solution for the phosphorus nutrition requirements of plants. Phosphorus is an essential nutrient for plants when it comes to RNA and DNA formation of the plants.
Learn MoreOrganic + NPK Liquid Gel Fertilizer
Introducing our Organic + Calcium Magnesium Liquid – a dynamic fusion of essential secondary nutrients. This revolutionary blend serves as a highly effective alternative to traditional soil conditioners, encompassing the key elements needed for robust plant growth in a readily absorbable form.
Learn MoreOrganic + NPK Liquid Gel Fertilizer
Super Phosphoric Acid 70% - the ultimate solution for optimizing plant nutrition, soil health, and irrigation efficiency. With its multi-functionality and rich source of phosphorus, our product is designed to meet the diverse needs of farmers, horticulturists, and growers. Whether you're cultivating greenhouse crops
Learn MoreOrganic + NPK Liquid Gel Fertilizer
The ORGANIC + NPK Liquid Gel 03:50:50 is a highly concentrated emulsion, combining macro and chelated micro elements along with an organic component proven to stimulate root development in plants.
Learn MoreOrganic + NPK Liquid Gel Fertilizer
ORGANIC + NPK 00:50:50 is a highly concentrated emulsion containing macro and chelated micro elements. It includes organic component which has proven beneficial effects upon plants by stimulating root development.
Learn MoreOrganic + NPK Liquid Gel Fertilizer
A complex fertilizer mixture of all three primary macronutrients, Organic + NPK Liquid Gel 10:26:26 is an all-around solution that delivers Nitrogen (N), Phosphorus (P), and Potassium (K) in a fixed ratio.
Learn MoreOrganic + NPK Liquid Gel Fertilizer
A product that is one of the most widely used variations of the NPK mixture fertilizers is NPK 19:19:19 which arguably is the most equitable mixture of all the three macronutrients. With Nitrogen, Phosphorus, and Potassium present in an equal ratio of 19:19:19 respectively.
Learn MoreOrganic + NPK Liquid Gel Fertilizer
An emulsion-based liquid mixture fertiliser made from the combination of the two essential macronutrients Phosphorus and Potassium in a ratio of 40:55. A combination that delivers both these nutrients in equal proportion leading to enhanced root development.
Learn MoreOrganic + NPK Liquid Gel Fertilizer
The ORGANIC + NPK Liquid Gel 00:50:60 is a specialized emulsion-based liquid fertilizer formulated to provide a balanced combination of essential macronutrients - Phosphorus (P) and Potassium (K) - in a precise ratio of 50:60.
Learn MoreOrganic + NPK Liquid Gel Fertilizer
Our NPK 07:40:20 liquid gel fertilizer has been carefully formulated to provide balanced nutrition to plants with the inclusion of 75 essential macro- and micro-elements. This advanced fertilizer blend offers optimal nutrient uptake, promotes healthy growth, and enhances overall plant development.
Learn MoreOrganic + NPK Liquid Gel Fertilizer
A complex fertilizer mixture of all three primary macronutrients, Organic + NPK Liquid Gel 35:10:10 is a comprehensive solution that delivers Nitrogen (N), Phosphorus (P), and Potash/Potassium (K) in a fixed ratio. With a significantly higher nitrogen content, this product is designed to promote robust root development and vigorous vegetative growth in crops. The high nitrogen concentration ensures enhanced enzyme activation within the plant, contributing to its strength and resilience against stress conditions. This leads to improved amino acid secretion and protein synthesis, which are essential for the plant's overall health.
Learn MoreOrganic + NPK Liquid Gel Fertilizer
Calcium Nitrate Fortified with Magnesium Pro is a highly efficient, fully water-soluble fertilizer that delivers essential nutrients—calcium (Ca), nitrate nitrogen (NO₃-N), magnesium (Mg), zinc (Zn), and boron (B)—in an easily absorbable form. This specialized formulation plays a crucial role in strengthening plant cell walls, improving nutrient transport, enhancing chlorophyll synthesis, and ensuring optimal enzymatic activity for robust growth and high yields. It prevents physiological disorders such as blossom end rot in tomatoes, bitter pit in apples, fruit cracking in citrus, and tip burns in leafy vegetables, which are often caused by calcium and magnesium deficiencies.
Learn MoreOrganic + NPK Liquid Gel Fertilizer
Unlock the potential of your crops with our advanced NPK Liquid Gel 11-11-08, a power-packed solution meticulously crafted to cater to the nutritional needs of plants during critical growth stages. This suspension formula, enriched with essential micronutrients like Zinc as ZnEDTA and Boron as B , ensures a robust and comprehensive approach to plant nutrition.
Learn More






Micronutrients Liquid Fertilizer
Micronutrients are essential for the crop growth and productivity .Although their requirement is extremely small, the quantity for soil application is quite large and thus expensive .
Learn MoreMicronutrients Liquid Fertilizer
Arihant’s Calcium Boron Liquid is a micronutrient product that delivers both Calcium and Boron to plants. A perfect combination of a secondary nutrient and a micronutrient that play vital roles in the plant growth process respectively.
Learn MoreMicronutrients Liquid Fertilizer
Our Magnesium Silicon Liquid is a highly effective blend of two essential secondary nutrients, providing a valuable alternative to conventional soil conditioners. This innovative formulation encompasses the crucial components found in traditional soil conditioners, delivering them to plants in a more readily consumable form.
Learn MoreMicronutrients Liquid Fertilizer
Arihant’s Liquid Boron 10% is a liquid micronutrient fertilizer which works as both preventive and curative solution to control the insufficiency and deficiency of boron in the crops. It is a micronutrient product that delivers Boron to plant.
Learn MoreMicronutrients Liquid Fertilizer
Zinc Gluconate is a highly bioavailable and efficient source of zinc, an essential micronutrient for plant growth and development. It plays a crucial role in enzyme activation, protein synthesis, chlorophyll formation, and stress tolerance. Zinc gluconate increases nutrient uptake, boosts resistance to environmental stress, and boosts overall crop productivity by giving plants an easily absorbed form of zinc.
Learn MoreMicronutrients Liquid Fertilizer
Our Mix Micronutrient with EDTA Mixer is a precision-engineered formulation developed to provide plants with a balanced and bioavailable supply of essential micronutrients. These micronutrients play a crucial role in enzymatic activities, metabolic functions, and overall physiological development of crops. The innovative incorporation of EDTA (Ethylenediaminetetraacetic Acid) ensures enhanced chelation, allowing plants to efficiently uptake, transport, and utilize nutrients for optimal growth.
Learn MoreMicronutrients Liquid Fertilizer
Our Zinc + Boron Liquid Gel Fertilizer is an innovative solution crafted to meet the micronutrient needs of diverse crops, driving robust growth, superior yields, and enhanced plant vitality. Leveraging cutting-edge S4 and EA2 technologies, this advanced formulation stands out for its superior quality, performance, and efficiency, ensuring sustainable agricultural success.
Learn More













Speciality Product
Secondary Nutrient Based - pH Controller Amorphous Silicon based Mineral Granule provides Plant available silica to plants. It improves nutrient efficiency of other fertilizers by absorbing nutrients and slowly releasing them when required. It increases water retention and provides improved aeration in soil. Magnesium is often referred to as the "powerhouse behind photosynthesis".
Learn MoreSpeciality Product
BIO STIMULANT
ENRICH ACTIVE POWDER is an innovative Plant Growth Promoter (PGP) designed to revolutionize agricultural practices and maximize crop yields.
Speciality Product
BIO STIMULANT
ENRICH ACTIVE PLUS POWDER is an innovative Plant Growth Promoter (PGP) designed to revolutionize agricultural practices and maximize crop yields.
Speciality Product
Soil Conditioner Granule
Enrich Granule PGP features a comprehensive blend of essential nutrients, including calcium (as Ca), magnesium (as Mg), and silicon (Si), in addition to organic matter and sulphur. These components play pivotal roles in supporting plant growth and soil fertility.
Speciality Product
Mycorrhizal Bio-fertilizer - Enzymatic Carrier baseUnleash the Power of Enzymatic Mycorrhiza VAM Powder Enzymatic Mycorrhiza VAM Powder is a premium, scientifically formulated blend of beneficial mycorrhizal fungi spores that form a symbiotic relationship with plant roots.
Learn MoreSpeciality Product
BIO STIMULANT
ALL IN ONE is an innovative Plant Growth Promoter (PGP) designed to revolutionize agricultural practices and maximize crop yields.This powerful fertilizer contains a unique blend of humic acid, amino acid, seaweed extract, nitrobenzene, fulvic acid, vitamin, creating a synergistic effect that promotes robust plant growth and health.
Speciality Product
BIO STIMULANT
Bio stimulants are an important tool for modern agriculture as part of an integrated crop management (ICM) system; helping make agriculture more sustainable and resilient. Bio stimulants differ from other agricultural inputs such as fertilizers and plant protection products because they utilize different mechanisms and work regardless of the presence of nutrients in the products.
Speciality Product
Antioxidant
pH Balancer Liquid is a specialized product designed to adjust the pH level of any agricultural product solutions and to soften water used in agriculture. It is made from high-quality materials that are safe and effective for agricultural use. pH Balancer Liquid is ideal for farmers and growers who want to optimize their fertilizer application and ensure soft water for their spray or fertigation solutions.
Speciality Product
Bio Fungicide liquid is prepared for foliar application on plants to prevent or correct nutrient deficiency that may limit crop growth and yield. It is nontoxic to plants when applied. It is approved as an ffective organic fungicide.It is a broad spectrum protective bio fungicide against key diseases in multiple crops.
Learn MoreSpeciality Product
Potassium Thiosulphate is a clear, chloride-free solution renowned for its high potassium and sulfur content, featuring a minimum of 25% Potash and 17% Sulphur. This versatile fertilizer acts as an effective nitrification inhibitor, which is crucial for crop cultivation and production. It enhances crop resilience against environmental stresses, offering potassium and sulfur in a highly soluble form.
Learn MoreSpeciality Product
Calcium Thiosulfate (CaTS) fertilizer is a versatile and effective nutrient source used primarily in agriculture and horticulture. Composed of calcium (Ca) and thiosulfate (S₂O₃), CaTS fertilizer is valued for its unique properties and benefits to plants.
Learn MoreSpeciality Product
Growth Booster is an advanced plant growth promoter that infiltrates rapidly into the plant body, promoting cytoplasmic streaming and transport within cells, It is a strong cell agent. It enhances fertilization and seed setting while increasing resistance to fungi and various environmental stresses. This product significantly improves flowering and fruiting in plants, boosts photosynthesis, and enhances the uptake of essential minerals.
Learn MoreSpeciality Product
Amino Acid 62.5% Liquid Fertilizer with Peptide Mixtures is a cutting-edge agricultural product engineered to deliver a potent combination of amino acids and peptides directly to crops.
Learn MoreSpeciality Product
A Powerhouse of Plant Growth-Promoting Rhizobacteria (PGPR) & Organic Nutrients.Arihant’s Organic Carbon Liquid is an innovative organic fertilizer enriched with Plant Growth-Promoting Rhizobacteria (PGPR), humic acid, amino acids, seaweed extract, fulvic acid, and hydrolyzed protein. This advanced formulation enhances soil fertility, plant immunity, and nutrient absorption, ensuring sustainable crop growth and higher yield.
Learn More









Chelated Fertilizer
Zinc-EDTA is a cutting-edge solution meticulously designed to meet the demanding needs of agricultural endeavours. With its exceptional purity, Zinc-EDTA guarantees swift and thorough dissolution, ensuring maximum efficacy in promoting crop health and yield.
Learn MoreChelated Fertilizer
Iron-EDTA represents a pinnacle in iron fertilization, meticulously formulated to meet the stringent demands of modern agriculture. Boasting exceptional purity, our product ensures swift and thorough dissolution, guaranteeing efficient delivery of iron to plants for maximum efficacy.
Learn MoreChelated Fertilizer
Manganese-EDTA represents a pinnacle in manganese fertilization, meticulously crafted to meet the exacting needs of modern agriculture. With its exceptional purity, our product ensures swift and thorough dissolution, guaranteeing the efficient delivery of manganese to plants for maximum effectiveness.
Learn MoreChelated Fertilizer
Copper-EDTA stands as a beacon of excellence in micronutrient fertilization, meticulously crafted to meet the exacting standards of modern agriculture. Renowned for its exceptional purity, our product ensures rapid and thorough dissolution, guaranteeing the efficient delivery of copper to plants for maximum effectiveness.
Learn MoreChelated Fertilizer
Magnesium EDTA stands as an indispensable source of readily available magnesium, often hailed as the "powerhouse behind photosynthesis" due to its pivotal role in this vital process. Magnesium serves as a central component of the chlorophyll molecule, the pigment responsible for capturing light energy during photosynthesis.
Learn MoreChelated Fertilizer
Calcium EDTA, a stable and water-soluble metal chelate, finds widespread application in agriculture and horticulture as a micronutrient, primarily utilized to prevent and rectify copper deficiencies in plants. Its versatility extends to various agricultural practices, making it a valuable component in foliage fertilizers, trickle irrigation systems, and as an additive absorbed in NPK formulations.
Learn MoreChelated Fertilizer
Chelated micronutrients represent a finely crafted blend of essential mineral elements vital for the health and productivity of a wide array of crops. Comprising zinc (Zn), copper (Cu), manganese (Mn), iron (Fe), boron (B), and molybdenum (Mo), these micronutrients play a crucial role in nurturing horticultural crops, as well as cereals, pulses, oilseeds, spices, and plantation crops.
Learn MoreChelated Fertilizer
Chelated micronutrients constitute a finely balanced amalgamation of essential mineral elements including Zinc (Zn), Copper (Cu), Manganese (Mn), Iron (Fe), Boron (B), and Molybdenum (Mo). These micronutrients are vital for nurturing a diverse range of crops, spanning horticultural produce to cereals, pulses, oilseeds, spices, and plantation crops.
Learn MoreChelated Fertilizer
Chelation is a process where the metals are turned into metal compounds which are easily taken up, and are beneficial for the crop and their growth. Micronutrient fertilizers (The series of Complete Amino Acids Chelated Micronutrient Fertilizer Mixture) available in liquid form which contain almost all Micronutrients in a balanced proportion.
Learn MoreChelated Fertilizer
Chelation is a process where the metals are turned into metal compounds which are easily taken up, and are beneficial for the crop and their growth. Micronutrient fertilizers (The series of Complete Amino Acids Chelated Micronutrient Fertilizer Mixture) available in powder form which contain almost all Micro nutrients in a balanced proportion.
Learn More









Micro Nutrient Fertilizer
Micronutrients play a critical role in ensuring optimal crop growth and productivity, with Zinc Sulphate emerging as a key player in this regard. Containing 21% zinc, this compound serves as an indispensable component of various enzyme systems crucial for energy production, protein synthesis, and growth regulation within plants. Zinc's influence on photosynthesis is particularly noteworthy, as it directly impacts the efficiency of this vital process, thus affecting overall plant vigor and productivity.
Learn MoreMicro Nutrient Fertilizer
Micronutrients play a pivotal role in fostering robust crop growth and enhancing productivity. Zinc Sulphate, comprising 33% zinc, emerges as a crucial contributor to this endeavor. Zinc serves as an indispensable component of numerous enzyme systems pivotal for energy production, protein synthesis, and growth regulation within plants.
Learn MoreMicro Nutrient Fertilizer
Iron stands as one of the indispensable 17 essential elements for plant health, frequently employed across lawn, turf, and landscape environments. Ferrous Sulfate fertilizer finds common usage in rectifying Chlorosis, a condition marked by the yellowing of leaves, by replenishing iron levels.
Learn MoreMicro Nutrient Fertilizer
Manganese is a pivotal element in plant physiology, playing a critical role in photosynthesis and exerting a significant influence on stress tolerance. Adequate levels of manganese not only support optimal photosynthetic activity but also enhance the plant's ability to withstand various environmental stressors.
Learn MoreMicro Nutrient Fertilizer
Copper Sulphate finds widespread application in agriculture, serving various functions critical for crop care and management. Primarily utilized as a fertilizer, it enriches soil with copper, an essential micronutrient vital for plant growth and development. By increasing the copper content of the soil, Copper Sulphate helps rectify deficiencies, particularly in peaty and acidic soils, creating a more hospitable environment conducive to robust plant growth.
Learn MoreMicro Nutrient Fertilizer
Magnesium Sulphate, commonly known as Epsom salt, emerges as a cornerstone in plant nutrition, offering a readily available source of magnesium, a mineral widely acknowledged as the "powerhouse behind photosynthesis." This essential element plays a pivotal role in plant growth and health by facilitating the metabolism of carbohydrates, a fundamental process for energy production and overall metabolic functions within plants.
Learn MoreMicro Nutrient Fertilizer
Boron's multifaceted role in plant physiology underscores its indispensability beyond merely facilitating calcium uptake. In addition to this crucial function, boron plays a pivotal role in regulating the delicate balance between sugar and starch within plants, facilitating the efficient translocation of sugars and carbohydrates throughout various plant tissues. Moreover, boron's involvement in pollination and seed production highlights its significance in ensuring reproductive success and sustaining plant populations.
Learn MoreMicro Nutrient Fertilizer
Boron serves as more than just a conduit for calcium uptake in plants; its multifaceted roles encompass critical functions essential for overall plant health and development. Beyond its pivotal role in calcium transport, boron is indispensable for maintaining a delicate equilibrium between sugar and starch levels within plants, facilitating the efficient translocation of these vital carbohydrates throughout various tissues.
Learn MoreMicro Nutrient Fertilizer
Micronutrients, comprising Zinc, Copper, Manganese, Iron, Boron, and Molybdenum, constitute an essential aspect of plant nutrition, crucial for the optimal growth and development of various crops. These mineral elements play a fundamental role in nurturing horticultural crops, cereals, pulses, oilseeds, spices, and plantation varieties, ensuring their health and productivity.
Learn MoreMicro Nutrient Fertilizer
Micronutrients, including Zinc, Copper, Manganese, Iron, Boron, and Molybdenum, constitute a vital aspect of plant nutrition, essential for the optimal growth and development of various crops. These mineral elements form a fine blend that nurtures not only horticultural crops but also cereals, pulses, oilseeds, spices, and plantation varieties, ensuring their health and productivity.
Learn More




















Potassium Humate
Potassium humate is a highly effective, water-soluble Shiny Flake product renowned for its high concentration of organic matter and potassium. This powerful combination not only enriches the soil physically, chemically, and biologically but also supplies one of the three essential nutrients that every plant needs for optimal growth.
Learn MorePotassium Humate
Super Potassium Humate is a highly efficient, water-soluble Shiny Flakes product known for its high concentration of organic matter and potassium. This dual-benefit product not only enhances soil quality on physical, chemical, and biological levels but also supplies potassium, one of the three essential nutrients every plant needs for healthy growth.
Learn MorePotassium Humate
Super Potassium Fulvate Humate is a premium, water-soluble Shiny Flakes product distinguished by its high concentration of organic matter and potassium. This potent combination significantly enhances soil quality on physical, chemical, and biological levels, making it a vital component for sustainable farming.
Learn MorePotassium Humate
Super Potassium Fulvate Humate (Norway Origin) is a top-tier, water-soluble Shiny Flakes product known for its high concentration of organic matter and potassium. This powerful combination significantly enhances soil quality on physical, chemical, and biological levels, providing one of the three essential nutrients that plants require for optimal growth. Its high solubility makes it easy to dilute in water, allowing farmers to seamlessly incorporate it into their traditional liquid humic acid mixtures.
Learn MoreHumic Acid
Humic Acid Liquid Fertilizer, derived from premium-grade leonardite, offers versatile applications as both a soil amendment and foliar spray. Its natural composition enhances the uptake of micronutrients by plants, promoting healthier growth and improved nutrient utilization.
Learn MoreHumic Acid
Humic Acid, extracted from natural-grade Leonardite or Lignite, serves as a fundamental raw material in agricultural products. It comprises a group of molecules that play a crucial role in enhancing plant growth by facilitating nutrient uptake and improving water retention in soils. These molecules bind to soil particles and plant roots, aiding in the efficient absorption of essential nutrients and moisture.
Learn MoreAmino Acid
Amino acids are categorized into two types: animal origin, derived from sources like duck feathers, and plant origin, sourced from plants such as soybeans and corn. Amino acid fertilizers are highly beneficial for plants as they are easily absorbed, transported, and utilized as nitrogen and carbon sources.
Learn MoreAmino Acid
Amino Acid Liquid Fertilizer, widely known as "AMINO GOLD" among farmers, stands out for its exceptional efficacy, especially on fruits and vegetables. It contains a rich blend of 9 groups of beneficial microorganisms alongside high-quality food-grade organic materials. This formulation ensures optimal nutrient availability and enhances soil health.
Learn MoreAmino Acid
Amino NPK granular represents a cutting-edge organic nitrogen fertilizer derived from monosodium glutamate residue through advanced production techniques and high-temperature granulation. This innovative fertilizer provides essential organic matter, nitrogen, and potassium to plants, effectively enhancing soil fertility and promoting robust root growth.
Learn MoreFulvic Acid
Fulvic acid 95% powder, also known as Biotechnology Fulvic Acid (BFA), represents a recent advancement in agricultural biotechnology. It is a bio-fermentation-derived material akin to fulvic acid, comprising a blend of specific bio-fermentation activity products. BFA offers a sustainable alternative to traditionally extracted humic or fulvic acids for applications in farming and animal husbandry.
Learn MoreFulvic Acid
Fulvic acid stands out as a vital component in modern agricultural practices, offering a plethora of benefits. Its profound impact on crop growth makes it a cornerstone in soil enhancement strategies. Opting for higher quality humic and fulvic acids amplifies these advantages significantly.
Learn MoreSeaweed Extract
Seaweed Extract is a rich source of natural plant hormones, essential nutrients, trace elements, and carbohydrates, including alginic acids and polysaccharides. With over 70 minerals, vitamins, and enzymes, seaweed offers a comprehensive nutritional package for plants. Its application in agriculture yields numerous benefits.
Learn MoreSeaweed Extract
Liquid Seaweed Fertilizer, derived from marine seaweed, is a potent agricultural asset containing a rich array of essential compounds. From cytokinins to oligomeric alginate potassium, betaine, mannitol, polysaccharides, iodine, microelements, and alginic polyphenols, its composition encompasses a wide spectrum of nutrients and bioactive substances.
Learn MoreSeaweed Extract
Seaweed Granular Fertilizer combines the potent properties of seaweed, humic acid, amino acids, and essential trace elements. This comprehensive blend is designed to nourish plants with a rich array of nutrients and bioactive compounds crucial for optimal growth and development.
Learn MoreBio Stimulant
Our Liquid Nitrobenzene is a scientifically formulated chemical comprising 20% Nitrobenzene, enriched with naturally sourced vegetable proteins. It serves as a potent budding stimulant, promoting robust yield growth across all crop varieties. We maintain large stocks to fulfill urgent and substantial buyer demands promptly.
Learn MoreBio Stimulant
Our Liquid Nitrobenzene is a scientifically formulated chemical containing 35% Nitrobenzene, enriched with naturally sourced vegetable proteins. It serves as a potent budding stimulant, promoting high yield growth across all crops. We maintain extensive stocks to meet urgent and large-scale buyer demands promptly.
Learn MoreBio Stimulant
Our Liquid Nitrobenzene is a cutting-edge chemical formulation with a high concentration of 70% Nitrobenzene, enhanced by naturally derived vegetable proteins. It acts as a potent budding stimulant, effectively promoting robust yield growth across diverse crop varieties. We maintain a substantial inventory to swiftly meet urgent and extensive buyer demands.
Learn MoreBio Stimulant
Brassinolide, commonly referred to as brassinos, is a natural plant hormone extensively researched for its potential as a fertilizer in agriculture. This hormone plays a vital role in regulating various aspects of plant growth, development, and immunity. Produced naturally by plants as required, brassinolides facilitate growth processes such as pollen formation, flower and fruit setting, and seed development.
Learn MoreBio Stimulant
All in One Granules" represent a groundbreaking innovation in biotechnology research, formulated through a unique blend of animal and vegetable products under precise scientific conditions. This granular form ensures optimal effectiveness in agricultural applications, providing superior output.
Learn MoreSticker
Silicon Spreader & Sticker is a new generation Silicone-based non-ionic adjuvant innovated by ultra-modern R & D centre of Arihant which can be used with fungicides, insecticides & herbicides, PGRs and fertilisers to enhance their performance and effectiveness.
Learn MoreSticker
Anionic Sticker represents a ground-breaking adjuvant boasting QUADRUPLE technology. Engineered for versatile application, it seamlessly integrates with insecticides, fungicides, herbicides, and foliar fertilizers. Its core function lies in augmenting adherence and dispersion, elevating the efficacy of applied molecules. By enhancing the performance over target organisms, it unlocks a new dimension of effectiveness.
Learn More

Mycorrhizal (VAM)
Dextrose, a sugar derived from corn, plays a crucial role when combined with liquid nitrogen by providing essential sugars that nourish bacteria as they become active in the soil. This process supports the initial stages of bacterial activity and enhances soil health.
Learn MoreMycorrhizal (VAM)
Talc is a very efficient Carrier for fertilizers since it helps the soil quality and also reduces water wastage since it improves fertilizer flow, reducing water pick-up
Learn MoreMycorrhizal (VAM)
Vesicular Arbuscular Mycorrhizal (VAM) fungi are crucial organisms capable of solubilizing abundant soil phosphates, thereby enhancing phosphorus availability to plants. Beyond nutrient enrichment, VAM fungi fortify plants, bolstering their ability to withstand disease pathogens, adverse weather conditions, and various pathogenic infections. This symbiotic relationship significantly augments nutrient uptake in host plants, facilitating increased absorption of water and essential minerals like phosphorus and nitrogen.
Learn MoreMycorrhizal (VAM)
Vesicular Arbuscular Mycorrhizal (VAM) fungi are essential organisms capable of solubilizing abundant soil phosphates, thereby enhancing phosphorus availability for plants. Beyond nutrient enrichment, VAM fungi fortify plants, imparting resilience against disease pathogens, adverse weather, and various pathogenic infections. This symbiotic association significantly augments nutrient uptake in host plants, facilitating increased absorption of water and essential minerals such as phosphorus and nitrogen.
Learn MoreMycorrhizal (ECTO)
In commercial forestry, the successful transplanting of crop trees to new locations often necessitates the presence of an ectomycorrhizal partner. This is particularly critical for trees that exhibit a high specificity towards their mycorrhizal fungi, or when planting occurs in environments where native fungal species may not naturally occur. This need is prominently observed in plantations involving obligate ectomycorrhizal trees like Eucalyptus and Pinus species.
Learn MoreMycorrhizal (ECTO)
In commercial forestry, the successful transplanting of crop trees to new locations often depends on having a suitable ectomycorrhizal partner. This is crucial for trees that exhibit a strong specificity towards their mycobiont, especially when they are planted in environments where native fungal species may not naturally occur. This necessity is particularly evident in plantations involving obligate ectomycorrhizal trees like Eucalyptus and Pinus species.
Learn MoreMycorrhizal (ECTO)
In commercial forestry, successful transplantation of crop trees to new locations often hinges on the presence of an ectomycorrhizal partner. This need is particularly critical for trees that exhibit specific requirements for their mycobiont, especially when they are planted in environments far from their native habitats and among unfamiliar fungal species. This necessity is well-documented in plantations involving obligate ectomycorrhizal trees like Eucalyptus and Pinus species.
Learn MoreBio Fertilizer Liquid
Azotobacter is a genus of free-living, nitrogen-fixing bacteria that plays a vital role in the nitrogen cycle. These bacteria are found in various soil environments and can thrive in both aerobic (oxygen-rich) and anaerobic (oxygen-depleted) conditions. They possess the unique ability to convert atmospheric nitrogen into a form usable by plants, thereby reducing the dependency on synthetic nitrogen fertilizers. Azotobacter also promotes plant growth through the production of growth-promoting substances, enhancing nutrient availability and root development.
Learn MoreBio Fertilizer Liquid
Rhizobium is a genus of nitrogen-fixing bacteria that forms a symbiotic relationship with leguminous plants. Rhizobium forms an endosymbiotic nitrogen-fixing association with the roots of legumes. These bacteria play a crucial role in biological nitrogen fixation, converting atmospheric nitrogen into a form that can be used by plants. Rhizobium bacteria colonize the roots of legumes and form specialized structures called nodules.
Learn MoreBio Fertilizer Liquid
Azospirillium is a genus of beneficial, plant growth-promoting bacteria commonly found in soil and rhizosphere environments. This gram-negative, motile bacterium is commonly found in the roots of monocots. It plays a crucial role in nitrogen fixation by converting atmospheric nitrogen into a form that plants can use, significantly reducing the need for chemical nitrogen fertilizers by up to 50%. These bacteria play a crucial role in agriculture by promoting plant growth and health through various mechanisms.
Learn MoreBio Fertilizer Liquid
Acetobacter is a versatile genus of bacteria known for its dual role in agriculture and industry. In agriculture, it functions as an aerobic nitrogen-fixing bacterium, thriving in the roots, stems, and leaves of plants like sugarcane and coffee. It produces growth-promoting substances such as Indole Acetic Acid and Gibberellic Acid, stimulating root proliferation and enhancing nutrient uptake, water absorption, and phosphate solubilization. This promotes robust growth and improves sugar recovery in sugarcane crops.
Learn MoreBio Fertilizer Liquid
Phosphorus, second only to nitrogen, is one of the most crucial mineral nutrients limiting crop growth. It is essential for plant development and growth but is often insoluble and unavailable to plants. Consequently, the amount of phosphorus accessible to plants is typically a small fraction of its total presence in the soil. Phosphate Solubilizing Bacteria (PSB) play a vital role by converting insoluble phosphates into soluble forms, making phosphorus available to plants, and enhancing crop growth.
Learn MoreBio Fertilizer Liquid
Potassium mobilizing bacteria (KMB) are beneficial microorganisms that play a vital role in improving crop growth. These bacteria have the unique ability to mobilize insoluble forms of potassium, making it more readily available for plants. By doing so, they enhance the nutrient uptake efficiency of crops, leading to faster and healthier growth.
Learn MoreBio Fertilizer Liquid
Consortia is a combination of more than one microorganism that, being in the rhizosphere, directly or indirectly influences the composition and productivity of natural plant communities. Consortia, also known as Bio NPK (Nitrogen, Phosphorus, and Potassium), are a combination of multiple beneficial microorganisms that work together to provide a comprehensive nutrient management solution for plants. These consortia consist of different strains of bacteria, fungi, and other beneficial microbes.
Learn MoreBio Fertilizer Liquid
Zinc solubilizing bacteria play a crucial role in enhancing plant growth and productivity by mobilizing zinc in the soil. These bacteria employ various mechanisms, one of which involves acidification. They secrete organic acids into the soil, which effectively sequester zinc cations, making them more available to plants. Additionally, the organic acids released by these microbes contribute to a decrease in the pH of the nearby soil, promoting zinc solubility.
Learn MoreBio Fertilizer Liquid
Phosphorus-solubilizing fungi are a beneficial group of microorganisms that play a vital role in converting insoluble phosphorus compounds into soluble forms that can be readily absorbed by plants. They achieve this by employing various mechanisms such as lowering the pH level of the soil, chelation, and mineralization processes. This transformation makes phosphorus more accessible for plant uptake and utilization.
Learn MoreBio Fertilizer Liquid
Sulphur oxidizers play a crucial role in converting elemental sulphur into plant-available sulfate. Sulphur is an essential element for pulse production and is involved in the formation of proteins, vitamins, and enzymes. It is a key component of amino acids such as cystine, cysteine, and methionine.
Learn MoreBio Fertilizer Liquid
Calcium-solubilizing bacteria are microorganisms that convert insoluble calcium into soluble forms, enhancing soil fertility and plant health. They possess enzymes like organic acids that break down calcium compounds in the soil, making them available for plants. Calcium is essential for plant growth and development, and these bacteria contribute to soil fertility and nutrient uptake. They can be found naturally in soil, the rhizosphere, and plant roots, forming a symbiotic relationship with plants.
Learn MoreBio Fertilizer Culture Liquid
Azotobacter is a genus of free-living, nitrogen-fixing bacteria that plays a vital role in the nitrogen cycle. These bacteria are found in various soil environments and can thrive in both aerobic (oxygen-rich) and anaerobic (oxygen-depleted) conditions. They possess the unique ability to convert atmospheric nitrogen into a form usable by plants, thereby reducing the dependency on synthetic nitrogen fertilizers. Azotobacter also promotes plant growth through the production of growth-promoting substances, enhancing nutrient availability and root development.
Learn MoreBio Fertilizer Culture Liquid
Rhizobium is a genus of nitrogen-fixing bacteria that forms a symbiotic relationship with leguminous plants. Rhizobium forms an endosymbiotic nitrogen-fixing association with the roots of legumes. These bacteria play a crucial role in biological nitrogen fixation, converting atmospheric nitrogen into a form that can be used by plants. Rhizobium bacteria colonize the roots of legumes and form specialized structures called nodules.
Learn MoreBio Fertilizer Culture Liquid
Azospirillium is a genus of beneficial, plant growth-promoting bacteria commonly found in soil and rhizosphere environments. This gram-negative, motile bacterium is commonly found in the roots of monocots. It plays a crucial role in nitrogen fixation by converting atmospheric nitrogen into a form that plants can use, significantly reducing the need for chemical nitrogen fertilizers by up to 50%. These bacteria play a crucial role in agriculture by promoting plant growth and health through various mechanisms.
Learn MoreBio Fertilizer Culture Liquid
Acetobacter is a versatile genus of bacteria known for its dual role in agriculture and industry. In agriculture, it functions as an aerobic nitrogen-fixing bacterium, thriving in the roots, stems, and leaves of plants like sugarcane and coffee. It produces growth-promoting substances such as Indole Acetic Acid and Gibberellic Acid, stimulating root proliferation and enhancing nutrient uptake, water absorption, and phosphate solubilization. This promotes robust growth and improves sugar recovery in sugarcane crops.
Learn MoreBio Fertilizer Culture Liquid
Phosphorus, second only to nitrogen, is one of the most crucial mineral nutrients limiting crop growth. It is essential for plant development and growth but is often insoluble and unavailable to plants. Consequently, the amount of phosphorus accessible to plants is typically a small fraction of its total presence in the soil. Phosphate Solubilizing Bacteria (PSB) play a vital role by converting insoluble phosphates into soluble forms, making phosphorus available to plants, and enhancing crop growth.
Learn MoreBio Fertilizer Culture Liquid
Potassium mobilizing bacteria (KMB) are beneficial microorganisms that play a vital role in improving crop growth. These bacteria have the unique ability to mobilize insoluble forms of potassium, making it more readily available for plants. By doing so, they enhance the nutrient uptake efficiency of crops, leading to faster and healthier growth.
Learn MoreBio Fertilizer Culture Liquid
Consortia is a combination of more than one microorganism that, being in the rhizosphere, directly or indirectly influences the composition and productivity of natural plant communities. Consortia, also known as Bio NPK (Nitrogen, Phosphorus, and Potassium), are a combination of multiple beneficial microorganisms that work together to provide a comprehensive nutrient management solution for plants. These consortia consist of different strains of bacteria, fungi, and other beneficial microbes.
Learn MoreBio Fertilizer Culture Liquid
Zinc solubilizing bacteria play a crucial role in enhancing plant growth and productivity by mobilizing zinc in the soil. These bacteria employ various mechanisms, one of which involves acidification. They secrete organic acids into the soil, which effectively sequester zinc cations, making them more available to plants. Additionally, the organic acids released by these microbes contribute to a decrease in the pH of the nearby soil, promoting zinc solubility.
Learn MoreBio Fertilizer Culture Liquid
Phosphorus-solubilizing fungi are a beneficial group of microorganisms that play a vital role in converting insoluble phosphorus compounds into soluble forms that can be readily absorbed by plants. They achieve this by employing various mechanisms such as lowering the pH level of the soil, chelation, and mineralization processes. This transformation makes phosphorus more accessible for plant uptake and utilization.
Learn MoreBio Fertilizer Culture Liquid
Sulphur oxidizers play a crucial role in converting elemental sulphur into plant-available sulfate. Sulphur is an essential element for pulse production and is involved in the formation of proteins, vitamins, and enzymes. It is a key component of amino acids such as cystine, cysteine, and methionine.
Learn MoreBio Fertilizer Culture Liquid
Calcium-solubilizing bacteria are microorganisms that convert insoluble calcium into soluble forms, enhancing soil fertility and plant health. They possess enzymes like organic acids that break down calcium compounds in the soil, making them available for plants. Calcium is essential for plant growth and development, and these bacteria contribute to soil fertility and nutrient uptake. They can be found naturally in soil, the rhizosphere, and plant roots, forming a symbiotic relationship with plants.
Learn MoreTalc Base Bio Fertilizer Powder
Azotobacter are free living bacteria that can fix atmospheric nitrogen into the soil, being a great source to obtain a natural bio fertilizer that can be used in the cultivation of most crops. Azotobacter has the ability to fix atmospheric nitrogen by the conversion to ammonia. Plants are able to utilize the ammonia as a nutrient. Azotobacter can accomplish nitrogen fixation by using three different enzymes which are termed as Nitrogenases. The enhanced versatility of Azotobacter bacteria makes the microbe attractive for agricultural purposes. The medium used in this product is Talc which enhances its effectiveness and gives optimum shelf life.
Learn MoreTalc Base Bio Fertilizer Powder
Rhizobium is a genus of nitrogen-fixing bacteria that forms a symbiotic relationship with leguminous plants. Rhizobium forms an endosymbiotic nitrogen-fixing association with the roots of legumes. These bacteria play a crucial role in biological nitrogen fixation, converting atmospheric nitrogen into a form that can be used by plants. Rhizobium bacteria colonize the roots of legumes and form specialized structures called nodules.
Learn MoreTalc Base Bio Fertilizer Powder
Azospirillium is a genus of beneficial, plant growth-promoting bacteria commonly found in soil and rhizosphere environments. This gram-negative, motile bacterium is commonly found in the roots of monocots. It plays a crucial role in nitrogen fixation by converting atmospheric nitrogen into a form that plants can use, significantly reducing the need for chemical nitrogen fertilizers by up to 50%. These bacteria play a crucial role in agriculture by promoting plant growth and health through various mechanisms.
Learn MoreTalc Base Bio Fertilizer Powder
Acetobacter is a versatile genus of bacteria known for its dual role in agriculture and industry. In agriculture, it functions as an aerobic nitrogen-fixing bacterium, thriving in the roots, stems, and leaves of plants like sugarcane and coffee. It produces growth-promoting substances such as Indole Acetic Acid and Gibberellic Acid, stimulating root proliferation and enhancing nutrient uptake, water absorption, and phosphate solubilization. This promotes robust growth and improves sugar recovery in sugarcane crops.
Learn MoreTalc Base Bio Fertilizer Powder
Phosphorus, second only to nitrogen, is one of the most crucial mineral nutrients limiting crop growth. It is essential for plant development and growth but is often insoluble and unavailable to plants. Consequently, the amount of phosphorus accessible to plants is typically a small fraction of its total presence in the soil. Phosphate Solubilizing Bacteria (PSB) play a vital role by converting insoluble phosphates into soluble forms, making phosphorus available to plants, and enhancing crop growth.
Learn MoreTalc Base Bio Fertilizer Powder
Potassium mobilizing bacteria (KMB) are beneficial microorganisms that play a vital role in improving crop growth. These bacteria have the unique ability to mobilize insoluble forms of potassium, making it more readily available for plants. By doing so, they enhance the nutrient uptake efficiency of crops, leading to faster and healthier growth.
Learn MoreTalc Base Bio Fertilizer Powder
Consortia is a combination of more than one microorganism that, being in the rhizosphere, directly or indirectly influences the composition and productivity of natural plant communities. Consortia, also known as Bio NPK (Nitrogen, Phosphorus, and Potassium), are a combination of multiple beneficial microorganisms that work together to provide a comprehensive nutrient management solution for plants. These consortia consist of different strains of bacteria, fungi, and other beneficial microbes.
Learn MoreTalc Base Bio Fertilizer Powder
Zinc solubilizing bacteria play a crucial role in enhancing plant growth and productivity by mobilizing zinc in the soil. These bacteria employ various mechanisms, one of which involves acidification. They secrete organic acids into the soil, which effectively sequester zinc cations, making them more available to plants. Additionally, the organic acids released by these microbes contribute to a decrease in the pH of the nearby soil, promoting zinc solubility.
Learn MoreTalc Base Bio Fertilizer Powder
Phosphorus-solubilizing fungi are a beneficial group of microorganisms that play a vital role in converting insoluble phosphorus compounds into soluble forms that can be readily absorbed by plants. They achieve this by employing various mechanisms such as lowering the pH level of the soil, chelation, and mineralization processes. This transformation makes phosphorus more accessible for plant uptake and utilization.
Learn MoreTalc Base Bio Fertilizer Powder
Sulphur oxidizers play a crucial role in converting elemental sulphur into plant-available sulfate. Sulphur is an essential element for pulse production and is involved in the formation of proteins, vitamins, and enzymes. It is a key component of amino acids such as cystine, cysteine, and methionine.
Learn MoreTalc Base Bio Fertilizer Powder
Calcium-solubilizing bacteria are microorganisms that convert insoluble calcium into soluble forms, enhancing soil fertility and plant health. They possess enzymes like organic acids that break down calcium compounds in the soil, making them available for plants. Calcium is essential for plant growth and development, and these bacteria contribute to soil fertility and nutrient uptake. They can be found naturally in soil, the rhizosphere, and plant roots, forming a symbiotic relationship with plants.
Learn MoreTalc Base Bio Fertilizer Granule
A free living nitrogen fixing bacteria closely associated with grasses. Azospirillum Bacteria is a gram negative motile bacteria associated with roots of monocots. It fixes the atmospheric nitrogen and makes it available to plants in a non-symbiotic manner that can replace 50% of the nitrogen fertilizer required by plants. It also secretes some fungicides ,enzymes but in a minute amount. Furthermore, being a talc based product it has enhanced effectiveness and shelf life.
Learn MoreTalc Base Bio Fertilizer Granule
Rhizobium is a genus of nitrogen-fixing bacteria that forms a symbiotic relationship with leguminous plants. Rhizobium forms an endosymbiotic nitrogen-fixing association with the roots of legumes. These bacteria play a crucial role in biological nitrogen fixation, converting atmospheric nitrogen into a form that can be used by plants. Rhizobium bacteria colonize the roots of legumes and form specialized structures called nodules.
Learn MoreTalc Base Bio Fertilizer Granule
Azospirillium is a genus of beneficial, plant growth-promoting bacteria commonly found in soil and rhizosphere environments. This gram-negative, motile bacterium is commonly found in the roots of monocots. It plays a crucial role in nitrogen fixation by converting atmospheric nitrogen into a form that plants can use, significantly reducing the need for chemical nitrogen fertilizers by up to 50%. These bacteria play a crucial role in agriculture by promoting plant growth and health through various mechanisms.
Learn MoreTalc Base Bio Fertilizer Granule
Acetobacter is a versatile genus of bacteria known for its dual role in agriculture and industry. In agriculture, it functions as an aerobic nitrogen-fixing bacterium, thriving in the roots, stems, and leaves of plants like sugarcane and coffee. It produces growth-promoting substances such as Indole Acetic Acid and Gibberellic Acid, stimulating root proliferation and enhancing nutrient uptake, water absorption, and phosphate solubilization. This promotes robust growth and improves sugar recovery in sugarcane crops.
Learn MoreTalc Base Bio Fertilizer Granule
Phosphorus, second only to nitrogen, is one of the most crucial mineral nutrients limiting crop growth. It is essential for plant development and growth but is often insoluble and unavailable to plants. Consequently, the amount of phosphorus accessible to plants is typically a small fraction of its total presence in the soil. Phosphate Solubilizing Bacteria (PSB) play a vital role by converting insoluble phosphates into soluble forms, making phosphorus available to plants, and enhancing crop growth.
Learn MoreTalc Base Bio Fertilizer Granule
Potassium mobilizing bacteria (KMB) are beneficial microorganisms that play a vital role in improving crop growth. These bacteria have the unique ability to mobilize insoluble forms of potassium, making it more readily available for plants. By doing so, they enhance the nutrient uptake efficiency of crops, leading to faster and healthier growth.
Learn MoreTalc Base Bio Fertilizer Granule
Consortia is a combination of more than one microorganism that, being in the rhizosphere, directly or indirectly influences the composition and productivity of natural plant communities. Consortia, also known as Bio NPK (Nitrogen, Phosphorus, and Potassium), are a combination of multiple beneficial microorganisms that work together to provide a comprehensive nutrient management solution for plants. These consortia consist of different strains of bacteria, fungi, and other beneficial microbes.
Learn MoreTalc Base Bio Fertilizer Granule
Zinc solubilizing bacteria play a crucial role in enhancing plant growth and productivity by mobilizing zinc in the soil. These bacteria employ various mechanisms, one of which involves acidification. They secrete organic acids into the soil, which effectively sequester zinc cations, making them more available to plants. Additionally, the organic acids released by these microbes contribute to a decrease in the pH of the nearby soil, promoting zinc solubility.
Learn MoreTalc Base Bio Fertilizer Granule
Phosphorus-solubilizing fungi are a beneficial group of microorganisms that play a vital role in converting insoluble phosphorus compounds into soluble forms that can be readily absorbed by plants. They achieve this by employing various mechanisms such as lowering the pH level of the soil, chelation, and mineralization processes. This transformation makes phosphorus more accessible for plant uptake and utilization.
Learn MoreTalc Base Bio Fertilizer Granule
Sulphur oxidizers play a crucial role in converting elemental sulphur into plant-available sulfate. Sulphur is an essential element for pulse production and is involved in the formation of proteins, vitamins, and enzymes. It is a key component of amino acids such as cystine, cysteine, and methionine.
Learn MoreTalc Base Bio Fertilizer Granule
Calcium-solubilizing bacteria are microorganisms that convert insoluble calcium into soluble forms, enhancing soil fertility and plant health. They possess enzymes like organic acids that break down calcium compounds in the soil, making them available for plants. Calcium is essential for plant growth and development, and these bacteria contribute to soil fertility and nutrient uptake. They can be found naturally in soil, the rhizosphere, and plant roots, forming a symbiotic relationship with plants.
Learn MoreDextrose Carrier Base Bio Fertilizer
Dextrose is a sugar derived from corn and research suggests that it is very valuable when mixed with liquid nitrogen. Dextrose has a very valuable role to play in supplying the sugars that feed the bacteria as the bacteria are just beginning to break dormancy and get active in the soil.
Learn MoreDextrose Carrier Base Bio Fertilizer
Dextrose is a sugar derived from corn and research suggests that it is very valuable when mixed with liquid nitrogen. Dextrose has a very valuable role to play in supplying the sugars that feed the bacteria as the bacteria are just beginning to break dormancy and get active in the soil.
Learn MoreDextrose Carrier Base Bio Fertilizer
Dextrose is a sugar derived from corn and research suggests that it is very valuable when mixed with liquid nitrogen. Dextrose has a very valuable role to play in supplying the sugars that feed the bacteria as the bacteria are just beginning to break dormancy and get active in the soil.
Learn MoreDextrose Carrier Base Bio Fertilizer
Dextrose is a sugar derived from corn and research suggests that it is very valuable when mixed with liquid nitrogen. Dextrose has a very valuable role to play in supplying the sugars that feed the bacteria as the bacteria are just beginning to break dormancy and get active in the soil.
Learn MoreDextrose Carrier Base Bio Fertilizer
Dextrose is a sugar derived from corn and research suggests that it is very valuable when mixed with liquid nitrogen. Dextrose has a very valuable role to play in supplying the sugars that feed the bacteria as the bacteria are just beginning to break dormancy and get active in the soil.
Learn MoreDextrose Carrier Base Bio Fertilizer
Dextrose is a sugar derived from corn and research suggests that it is very valuable when mixed with liquid nitrogen. Dextrose has a very valuable role to play in supplying the sugars that feed the bacteria as the bacteria are just beginning to break dormancy and get active in the soil.
Learn MoreDextrose Carrier Base Bio Fertilizer
Dextrose is a sugar derived from corn and research suggests that it is very valuable when mixed with liquid nitrogen. Dextrose has a very valuable role to play in supplying the sugars that feed the bacteria as the bacteria are just beginning to break dormancy and get active in the soil.
Learn MoreDextrose Carrier Base Bio Fertilizer
Dextrose is a sugar derived from corn and research suggests that it is very valuable when mixed with liquid nitrogen. Dextrose has a very valuable role to play in supplying the sugars that feed the bacteria as the bacteria are just beginning to break dormancy and get active in the soil.
Learn MoreDextrose Carrier Base Bio Fertilizer
Dextrose is a sugar derived from corn and research suggests that it is very valuable when mixed with liquid nitrogen. Dextrose has a very valuable role to play in supplying the sugars that feed the bacteria as the bacteria are just beginning to break dormancy and get active in the soil.
Learn MoreDextrose Carrier Base Bio Fertilizer
Dextrose is a sugar derived from corn and research suggests that it is very valuable when mixed with liquid nitrogen. Dextrose has a very valuable role to play in supplying the sugars that feed the bacteria as the bacteria are just beginning to break dormancy and get active in the soil.
Learn MoreBio Fertilizer Culture Liquid
Bacillus subtilis is a biofungicide and Plant growth promoting rhizobacteria (PGPR), which colonizes the roots and protects the root system of the plant. It enhances the N2 fixation, solubilizes the soil phosphorus, and produces siderophores having biocontrol potential (promote plant growth & suppress pathogen growth).
Learn More

Bio Pesticide Liquid
Trichoderma viride is a high-efficiency organic biological agent. It produces antibiotics, nutrient competition, parasitic, cell-wall degradation, enzymes, and induced plant resistance mechanisms, which have antagonism effect on a variety of plant pathogenic fungi. Protection and treatment can effectively control soil spread fungus diseases with dual effect.
Learn MoreBio Pesticide Liquid
Trichoderma grows on the surface of roots, where it provides disease control and enhances root growth. Its spores survive in the soil, but the food it lives on is mostly secreted from the root surface. Since the fungus multiplies on its own, it is different from seed-applied fungicides.
Learn MoreBio Pesticide Liquid
Beauveria Bassiana fungus is a fungus that grows naturally in soils around the world. Acting as a parasite on various arthropod species, causing white muscardine disease; It widely used as a sprayed biological insecticide to control a great many pests such as bed bugs, termites, thrips, whiteflies, aphids, and different beetles.
Learn MoreBio Pesticide Liquid
Metarhizium species (Metschnikoff) Sorokin, also known as green muscardine fungi, have long been recognized for their biological control potential against arthropods. The species level name of one of the more widely researched Metarhizium species (M. anisopliae) was derived from this beetle. Morphological features for identifying Metarhizium species can be imprecise as there can often be overlap of characters among species. Molecular techniques have shown that what used to be called M. anisopliae represents a complex of nine species.
Learn MoreBio Pesticide Liquid
The nematophagous fungus Pochonia chlamydosporia var. chlamydosporia is one of the most studied biological control agents The nematophagous fungus Pochonia chlamydosporia var. chlamydosporia is one of the most studied biological control agents,Rotylenchulus. In this paper we present highlights from more than three decades of worldwide research on this biological control agent. We cover different aspects and key components of the complex plant-fungus-nematode tri-trophic interaction, an interaction that needs to be addressed to ensure the efficient use of P. chlamydosporia as a biopesticide as part of an integrated pest management approach.
Learn MoreBio Pesticide Liquid
Fluorescent Pseudomonads belong to plant Growth Promoting Rhizobacteria (PGPR), the important group of bacteria that play a major role in the plant growth promotion, induced systemic resistance, biological control of pathogens etc. Many strains of Pseudomonas fluorescens are known to enhance plant growth promotion and reduce severity of various diseases.
Learn MoreBio Pesticide Liquid
Chemical insecticides play an important role in the control of plant damage and plant diseases. However, extensive use of these products has led to the disruption of ecosystems because of several reasons such as death of non-target species, accumulation of pesticide residues in the environment and food, and buildup of pesticide resistance in the target species. Biological control is one of the alternatives to chemical pesticides and it can be described as the limitation of the abundance of living organisms and their products by other living organisms.
Learn MoreBio Pesticide Culture Liquid
Trichoderma viride is a high-efficiency organic biological agent. It produces antibiotics, nutrient competition, parasitic, cell-wall degradation, enzymes, and induced plant resistance mechanisms, which have antagonism effect on a variety of plant pathogenic fungi. Protection and treatment can effectively control soil spread fungus diseases with dual effect.
Learn MoreBio Pesticide Culture Liquid
Trichoderma grows on the surface of roots, where it provides disease control and enhances root growth. Its spores survive in the soil, but the food it lives on is mostly secreted from the root surface. Since the fungus multiplies on its own, it is different from seed-applied fungicides.
Learn MoreBio Pesticide Culture Liquid
Beauveria Bassiana fungus is a fungus that grows naturally in soils around the world. Acting as a parasite on various arthropod species, causing white muscardine disease; It widely used as a sprayed biological insecticide to control a great many pests such as bed bugs, termites, thrips, whiteflies, aphids, and different beetles.
Learn MoreBio Pesticide Culture Liquid
Metarhizium species (Metschnikoff) Sorokin, also known as green muscardine fungi, have long been recognized for their biological control potential against arthropods. The species level name of one of the more widely researched Metarhizium species (M. anisopliae) was derived from this beetle. Morphological features for identifying Metarhizium species can be imprecise as there can often be overlap of characters among species. Molecular techniques have shown that what used to be called M. anisopliae represents a complex of nine species.
Learn MoreBio Pesticide Culture Liquid
The nematophagous fungus Pochonia chlamydosporia var. chlamydosporia is one of the most studied biological control agents The nematophagous fungus Pochonia chlamydosporia var. chlamydosporia is one of the most studied biological control agents,Rotylenchulus. In this paper we present highlights from more than three decades of worldwide research on this biological control agent. We cover different aspects and key components of the complex plant-fungus-nematode tri-trophic interaction, an interaction that needs to be addressed to ensure the efficient use of P. chlamydosporia as a biopesticide as part of an integrated pest management approach.
Learn MoreBio Pesticide Culture Liquid
Fluorescent Pseudomonads belong to plant Growth Promoting Rhizobacteria (PGPR), the important group of bacteria that play a major role in the plant growth promotion, induced systemic resistance, biological control of pathogens etc. Many strains of Pseudomonas fluorescens are known to enhance plant growth promotion and reduce severity of various diseases.
Learn MoreBio Pesticide Culture Liquid
Chemical insecticides play an important role in the control of plant damage and plant diseases. However, extensive use of these products has led to the disruption of ecosystems because of several reasons such as death of non-target species, accumulation of pesticide residues in the environment and food, and buildup of pesticide resistance in the target species. Biological control is one of the alternatives to chemical pesticides and it can be described as the limitation of the abundance of living organisms and their products by other living organisms.
Learn MoreTalc Base Bio Pesticide Powder
Trichoderma viride is a high-efficiency organic biological agent. It produces antibiotics, nutrient competition, parasitic, cell-wall degradation, enzymes, and induced plant resistance mechanisms, which have antagonism effect on a variety of plant pathogenic fungi. Protection and treatment can effectively control soil spread fungus diseases with dual effect.
Learn MoreTalc Base Bio Pesticide Powder
Trichoderma grows on the surface of roots, where it provides disease control and enhances root growth. Its spores survive in the soil, but the food it lives on is mostly secreted from the root surface. Since the fungus multiplies on its own, it is different from seed-applied fungicides.
Learn MoreTalc Base Bio Pesticide Powder
Beauveria Bassiana fungus is a fungus that grows naturally in soils around the world. Acting as a parasite on various arthropod species, causing white muscardine disease; It widely used as a sprayed biological insecticide to control a great many pests such as bed bugs, termites, thrips, whiteflies, aphids, and different beetles.
Learn MoreTalc Base Bio Pesticide Powder
Metarhizium species (Metschnikoff) Sorokin, also known as green muscardine fungi, have long been recognized for their biological control potential against arthropods. The species level name of one of the more widely researched Metarhizium species (M. anisopliae) was derived from this beetle. Morphological features for identifying Metarhizium species can be imprecise as there can often be overlap of characters among species. Molecular techniques have shown that what used to be called M. anisopliae represents a complex of nine species.
Learn MoreTalc Base Bio Pesticide Powder
The nematophagous fungus Pochonia chlamydosporia var. chlamydosporia is one of the most studied biological control agents The nematophagous fungus Pochonia chlamydosporia var. chlamydosporia is one of the most studied biological control agents,Rotylenchulus. In this paper we present highlights from more than three decades of worldwide research on this biological control agent. We cover different aspects and key components of the complex plant-fungus-nematode tri-trophic interaction, an interaction that needs to be addressed to ensure the efficient use of P. chlamydosporia as a biopesticide as part of an integrated pest management approach.
Learn MoreTalc Base Bio Pesticide Powder
Fluorescent Pseudomonads belong to plant Growth Promoting Rhizobacteria (PGPR), the important group of bacteria that play a major role in the plant growth promotion, induced systemic resistance, biological control of pathogens etc. Many strains of Pseudomonas fluorescens are known to enhance plant growth promotion and reduce severity of various diseases.
Learn MoreTalc Base Bio Pesticide Powder
Chemical insecticides play an important role in the control of plant damage and plant diseases. However, extensive use of these products has led to the disruption of ecosystems because of several reasons such as death of non-target species, accumulation of pesticide residues in the environment and food, and buildup of pesticide resistance in the target species. Biological control is one of the alternatives to chemical pesticides and it can be described as the limitation of the abundance of living organisms and their products by other living organisms.
Learn MoreTalc Base Bio Pesticide Granule
Trichoderma viride is a high-efficiency organic biological agent. It produces antibiotics, nutrient competition, parasitic, cell-wall degradation, enzymes, and induced plant resistance mechanisms, which have antagonism effect on a variety of plant pathogenic fungi. Protection and treatment can effectively control soil spread fungus diseases with dual effect.
Learn MoreTalc Base Bio Pesticide Granule
Trichoderma grows on the surface of roots, where it provides disease control and enhances root growth. Its spores survive in the soil, but the food it lives on is mostly secreted from the root surface. Since the fungus multiplies on its own, it is different from seed-applied fungicides.
Learn MoreTalc Base Bio Pesticide Granule
Beauveria Bassiana fungus is a fungus that grows naturally in soils around the world. Acting as a parasite on various arthropod species, causing white muscardine disease; It widely used as a sprayed biological insecticide to control a great many pests such as bed bugs, termites, thrips, whiteflies, aphids, and different beetles.
Learn MoreTalc Base Bio Pesticide Granule
Metarhizium species (Metschnikoff) Sorokin, also known as green muscardine fungi, have long been recognized for their biological control potential against arthropods. The species level name of one of the more widely researched Metarhizium species (M. anisopliae) was derived from this beetle. Morphological features for identifying Metarhizium species can be imprecise as there can often be overlap of characters among species. Molecular techniques have shown that what used to be called M. anisopliae represents a complex of nine species.
Learn MoreTalc Base Bio Pesticide Granule
The nematophagous fungus Pochonia chlamydosporia var. chlamydosporia is one of the most studied biological control agents The nematophagous fungus Pochonia chlamydosporia var. chlamydosporia is one of the most studied biological control agents,Rotylenchulus. In this paper we present highlights from more than three decades of worldwide research on this biological control agent. We cover different aspects and key components of the complex plant-fungus-nematode tri-trophic interaction, an interaction that needs to be addressed to ensure the efficient use of P. chlamydosporia as a biopesticide as part of an integrated pest management approach.
Learn MoreTalc Base Bio Pesticide Granule
Fluorescent Pseudomonads belong to plant Growth Promoting Rhizobacteria (PGPR), the important group of bacteria that play a major role in the plant growth promotion, induced systemic resistance, biological control of pathogens etc. Many strains of Pseudomonas fluorescens are known to enhance plant growth promotion and reduce severity of various diseases.
Learn MoreTalc Base Bio Pesticide Granule
Chemical insecticides play an important role in the control of plant damage and plant diseases. However, extensive use of these products has led to the disruption of ecosystems because of several reasons such as death of non-target species, accumulation of pesticide residues in the environment and food, and buildup of pesticide resistance in the target species. Biological control is one of the alternatives to chemical pesticides and it can be described as the limitation of the abundance of living organisms and their products by other living organisms.
Learn MoreBio Pesticide Liquid
Bacillus thuringiensis kurstaki (Btk) is a strain of Bt specifically used for controlling caterpillars in agricultural and garden settings. This strain produces crystal proteins (Cry proteins) that are toxic to caterpillars. When ingested by caterpillars, these proteins paralyze the insect's digestive system, causing them to stop feeding and eventually die from starvation.
Learn MoreBio Pesticide Liquid
Bacillus thuringiensis Israelensis (Bti) is a strain of Bacillus thuringiensis that specifically targets mosquito larvae and other dipteran insects. It has gained recognition as an effective and environmentally friendly tool for mosquito control.
Learn MoreBio Pesticide Culture Liquid
Bacillus thuringiensis kurstaki (Btk) is a strain of Bt specifically used for controlling caterpillars in agricultural and garden settings. This strain produces crystal proteins (Cry proteins) that are toxic to caterpillars. When ingested by caterpillars, these proteins paralyze the insect's digestive system, causing them to stop feeding and eventually die from starvation.
Learn MoreTalc Base Bio Pesticide Granule
Bacillus thuringiensis kurstaki (Btk) is a strain of Bt specifically used for controlling caterpillars in agricultural and garden settings. This strain produces crystal proteins (Cry proteins) that are toxic to caterpillars. When ingested by caterpillars, these proteins paralyze the insect's digestive system, causing them to stop feeding and eventually die from starvation.
Learn MoreTalc Base Bio Pesticide Powder
Bacillus thuringiensis kurstaki (Btk) is a strain of Bt specifically used for controlling caterpillars in agricultural and garden settings. This strain produces crystal proteins (Cry proteins) that are toxic to caterpillars. When ingested by caterpillars, these proteins paralyze the insect's digestive system, causing them to stop feeding and eventually die from starvation.
Learn MoreBio Pesticide Culture Liquid
Bacillus thuringiensis Israelensis (Bti) is a strain of Bacillus thuringiensis that specifically targets mosquito larvae and other dipteran insects. It has gained recognition as an effective and environmentally friendly tool for mosquito control.
Learn MoreTalc Base Bio Pesticide Granule
Bacillus thuringiensis Israelensis (Bti) is a strain of Bacillus thuringiensis that specifically targets mosquito larvae and other dipteran insects. It has gained recognition as an effective and environmentally friendly tool for mosquito control.
Learn MoreTalc Base Bio Pesticide Powder
Bacillus thuringiensis Israelensis (Bti) is a strain of Bacillus thuringiensis that specifically targets mosquito larvae and other dipteran insects. It has gained recognition as an effective and environmentally friendly tool for mosquito control.
Learn MoreDextrose Carrier Base Bio Pesticide
Trichoderma viride is a high-efficiency organic biological agent. It produces antibiotics, nutrient competition, parasitic, cell-wall degradation, enzymes, and induced plant resistance mechanisms, which have antagonism effect on a variety of plant pathogenic fungi. Protection and treatment can effectively control soil spread fungus diseases with dual effect.
Learn MoreDextrose Carrier Base Bio Pesticide
Trichoderma grows on the surface of roots, where it provides disease control and enhances root growth. Its spores survive in the soil, but the food it lives on is mostly secreted from the root surface. Since the fungus multiplies on its own, it is different from seed-applied fungicides.
Learn MoreDextrose Carrier Base Bio Pesticide
Beauveria Bassiana fungus is a fungus that grows naturally in soils around the world. Acting as a parasite on various arthropod species, causing white muscardine disease; It widely used as a sprayed biological insecticide to control a great many pests such as bed bugs, termites, thrips, whiteflies, aphids, and different beetles.
Learn MoreDextrose Carrier Base Bio Pesticide
Metarhizium species (Metschnikoff) Sorokin, also known as green muscardine fungi, have long been recognized for their biological control potential against arthropods. The species level name of one of the more widely researched Metarhizium species (M. anisopliae) was derived from this beetle. Morphological features for identifying Metarhizium species can be imprecise as there can often be overlap of characters among species. Molecular techniques have shown that what used to be called M. anisopliae represents a complex of nine species.
Learn MoreDextrose Carrier Base Bio Pesticide
The nematophagous fungus Pochonia chlamydosporia var. chlamydosporia is one of the most studied biological control agents against plant (semi-) endo-parasitic nematodes of the genera Globodera, Heterodera, Meloidogyne, Nacobbus and, more recently,Rotylenchulus. In this paper we present highlights from more than three decades of worldwide research on this biological controlagent. We cover different aspects and key components of the complex plant-fungus-nematode tri-trophic interaction, an interaction that needs to be addressed to ensure the efficient use of P. chlamydosporia as a biopesticide as part of an integrated pest management approach.
Learn MoreDextrose Carrier Base Bio Pesticide
Fluorescent Pseudomonads belong to plant Growth Promoting Rhizobacteria (PGPR), the important group of bacteria that play a major role in the plant growth promotion, induced systemic resistance, biological control of pathogens etc. Many strains of Pseudomonas fluorescens are known to enhance plant growth promotion and reduce severity of various diseases. The efficacy of bacterial antagonists in controlling fungal diseases was often better as alone, and sometimes in combination with fungicides. The present review refers to occurrence, distribution, mechanism, growth requirements of Pseudomonas fluorescens and diseases controlled by the bacterial antagonist in different agricultural and horticultural crops were discussed. The literature in this review helps in future research programmes that aim to promote Pseudomonas fluorescens as a potential bio-pesticide for augmentative biological control of many diseases of agriculture and horticultural importance.
Learn MoreDextrose Carrier Base Bio Pesticide
Chemical insecticides play an important role in the control of plant damage and plant diseases. However, extensive use of these products has led to the disruption of ecosystems because of several reasons such as death of non-target species, accumulation of pesticide residues in the environment and food, and buildup of pesticide resistance in the target species. Biological control is one of the alternatives to chemical pesticides and it can be described as the limitation of the abundance of living organisms and their products by other living organisms. Predators, parasitoids, fungi and other beneficial organisms can be used for the biocontrol of insect pests. The fungus Verticillium lecanii is one of the members of Deuteromycetes and it can be used for crop protection.
Learn MoreDextrose Carrier Base Bio Pesticide
Paecilomyces is a cosmopolitan fungus that is mainly known for its nematophagous capacity, but it has also been reported as an insect parasite and biological control agent of several fungi and phytopathogenic bacteria through different mechanisms of action
Learn MoreDextrose Carrier Base Bio Pesticide
Bacillus thuringiensis is a naturally occurring soil bacterium that causes disease on insect pests. It is accepted in organic farming and is considered ideal for pest management due to its low cost, ease of application, high virulence and narrow host specificity. Thus, Bacillus thuringiensis is regarded as environmentally friendly with no toxic effects on natural enemies and humans. The activity of Bacillus thuringiensis is due to toxins produced by this bacterium.
Learn MoreBio Pesticide Culture Liquid
Bacillus subtilis is a biofungicide and Plant growth promoting rhizobacteria (PGPR), which colonizes the roots and protects the root system of the plant. It enhances the N2 fixation, solubilizes the soil phosphorus, and produces siderophores having biocontrol potential (promote plant growth & suppress pathogen growth). Help plants to produce secondary metabolites, regulate intracellular phytohormones, and increase plant stress tolerance. Provide healthy growth to the plant and root. Bacillus subtilis is a cutting-edge, eco-friendly solution that provides both preventive and curative action against fungal pathogens affecting crops. Derived from natural soil-dwelling bacteria, Bacillus subtilis offers a biological approach to disease management, unlike chemical fungicides. It acts as a biocontrol agent, forming a protective shield around plant roots, stems, and leaves, while fostering a healthy, balanced microbial environment that supports plant vigour and resilience.
Learn MoreBio Pesticide Liquid
Bacillus subtilis is a biofungicide and Plant growth promoting rhizobacteria (PGPR), which colonizes the roots and protects the root system of the plant. It enhances the N2 fixation, solubilizes the soil phosphorus, and produces siderophores having biocontrol potential (promote plant growth & suppress pathogen growth).
Learn MoreTalc Base Bio Pesticide Powder
Bacillus subtilis is a biofungicide and Plant growth promoting rhizobacteria (PGPR), which colonizes the roots and protects the root system of the plant. It enhances the N2 fixation, solubilizes the soil phosphorus, and produces siderophores having biocontrol potential (promote plant growth & suppress pathogen growth).
Learn MoreTalc Base Bio Pesticide Granule
Bacillus subtilis is a biofungicide and Plant growth promoting rhizobacteria (PGPR), which colonizes the roots and protects the root system of the plant. It enhances the N2 fixation, solubilizes the soil phosphorus, and produces siderophores having biocontrol potential (promote plant growth & suppress pathogen growth).
Learn More









Water Soluble Fertilizer
Arihant Group’s NPK 19:19:19 is a high-quality, water-soluble fertilizer formulated to enhance fertigation efficiency. In its crystalline powder form, it dissolves completely in water, ensuring the swift release of essential nutrients—nitrogen, phosphorus, and potassium—directly at the plant's root zone. This ensures rapid absorption and utilization throughout the plant system, promoting vigorous growth and robust development.
Learn MoreWater Soluble Fertilizer
Arihant Group’s NPK 13:40:13 is a premium, water-soluble fertilizer designed to enhance fertigation efficiency. In its crystalline powder form, it dissolves completely in water, facilitating the swift release of essential nutrients—nitrogen, phosphorus, and potassium—directly at the root zone. This ensures rapid absorption and utilization throughout the plant system, promoting healthy growth and robust development.
Learn MoreWater Soluble Fertilizer
Arihant Group’s NPK 13:00:45 is a high-quality, water-soluble potassium nitrate fertilizer designed to optimize fertigation. In its crystalline form, it dissolves completely in water, ensuring the efficient release of essential nutrients—nitrogen (N) and potassium (K)—directly at the root zone. This promotes rapid absorption and effective distribution throughout the plant system, enhancing overall growth and development.
Learn MoreWater Soluble Fertilizer
Arihant Group’s NPK 12:61:00 is a superior, water-soluble mono ammonium phosphate fertilizer designed to enhance fertigation efficiency. This crystalline fertilizer dissolves completely in water, ensuring that essential nutrients—nitrogen (N) and phosphorus (P)—are quickly released at the root zone. This rapid release facilitates effective absorption and distribution throughout the plant system, promoting healthy and robust growth.
Learn MoreWater Soluble Fertilizer
Arihant Group’s NPK 00:52:34 is a premium, water-soluble mono potassium phosphate fertilizer designed to optimize fertigation. In its crystalline form, it dissolves completely in water, ensuring the efficient release of essential nutrients—phosphorus (P) and potassium (K)—directly at the root zone.
Learn MoreWater Soluble Fertilizer
Arihant Group’s NPK 00:00:50 is a high-quality, water-soluble potassium sulfate (SOP) fertilizer designed to optimize fertigation. In its crystalline form, it dissolves completely in water, ensuring the efficient release of essential nutrients—primarily potassium—directly at the root zone. This promotes rapid absorption and effective distribution throughout the plant system, enhancing overall growth and development.
Learn MoreWater Soluble Fertilizer
Arihant’s NPK 20-20-20 powder stands as a versatile fertilizer essential for fostering robust plant growth across agriculture, horticulture, and gardening. This balanced blend comprises equal parts of nitrogen (N), phosphorus (P), and potassium (K), fundamental nutrients vital for overall plant development.
Learn MoreWater Soluble Fertilizer
Arihant Group’s Calcium Nitrate Granule is a high-quality, water-soluble fertilizer designed to optimize fertigation. In its granular form, it dissolves completely in water, ensuring the efficient release of essential nutrients—calcium (Ca) and nitrogen (N)—directly at the root zone. This promotes rapid absorption and effective distribution throughout the plant system, enhancing overall growth and development.
Learn MoreWater Soluble Fertilizer
Arihant Group’s Boronated Calcium Nitrate Granule is a high-quality, water-soluble fertilizer designed to optimize fertigation. In its granular form, it dissolves completely in water, ensuring the efficient release of essential nutrients—calcium (Ca), nitrogen (N), and boron (B)—directly at the root zone.
Learn MoreWater Soluble Fertilizer
Arihant Group’s Potassium Schoenite is a premium, water-soluble fertilizer designed to enhance fertigation efficiency. In its crystalline powder form, it dissolves completely in water, ensuring the swift release of essential nutrients—potassium (K) and magnesium (Mg)—directly at the root zone. This promotes rapid absorption and effective distribution throughout the plant system, enhancing overall growth and development.
Learn MoreAt our manufacturing unit, quality assurance is our top priority. We adhere to strict quality control measures throughout the production process to ensure that our fertilizers meet the highest industry standards. Our quality assurance process includes:
We source only the finest quality raw materials from reputable suppliers, ensuring purity, efficacy, and consistency in our formulations.
Our cutting-edge manufacturing facilities are managed by highly qualified individuals who follow strict production guidelines to preserve the integrity and quality of our products. They are fully equipped with cutting-edge technology.
Before packaging and distribution, our fertilizers undergo comprehensive testing and analysis in our laboratory facilities to verify nutrient content, purity, and effectiveness.
We are committed to continuous improvement and innovation, regularly evaluating and refining our manufacturing processes to enhance product quality, efficiency, and sustainability
As a business-to-business enterprise, we acknowledge the significance of a dependable supply chain in guaranteeing smooth operations for our customers. We can effectively manage the purchase, shipping, and delivery of bulk agricultural materials to fertilizer manufacturing facilities worldwide thanks to our wide network of suppliers and logistical partners. We can deliver prompt and economical solutions because of our partnership of expertise and logistical ability, giving our clients peace of mind while they concentrate on their primary business operations
At Arihant, customer satisfaction is at the heart of everything we do. We are committed to providing exceptional service and support to our customers, including:
Our team of agronomists and agricultural experts is available to provide technical assistance, agronomic advice, and recommendations to help maximize crop yield and profitability.
Contact UsWe prioritize prompt and reliable delivery to ensure that our customers receive their orders in a timely manner, minimizing downtime and maximizing productivity.
Contact UsWe value feedback from our customers and actively seek input to continually improve our products and services continually. Our customer support team is always available to address questions, concerns, and feedback promptly.
Contact UsWe make it our business to advance your business. Get in touch to find out more.
ANBR ELIXIR PVT LTD
PLOT NO. 5144, NEAR PRIME INDUSTRIES, SEVEN WATER TANK ROAD,
NEAR PARAS CHOWKDI, G.I.D.C. INDUSTRIAL ESTATE,
ANKLESHWAR – 393 002.
DIST. BHARUCH, GUJARAT
ANBR ELIXIR PRIVATE LIMITED
Plot No. 10008-3, Near BEIL,
GIDC, Ankleshwar,
Dist :-Bharuch, 393002, Gujarat
